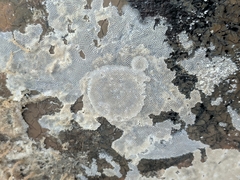
Membraniporidae

©juliabohemian, some rights reserved (CC-BY-NC)
©marianapitag, some rights reserved (CC-BY-NC)
©marianapitag, some rights reserved (CC-BY-NC)
©marianapitag, some rights reserved (CC-BY-NC)
©trinityj, some rights reserved (CC-BY-NC)
©trinityj, some rights reserved (CC-BY-NC)
©ben_leblanc00, some rights reserved (CC-BY-NC)
©Cricket Raspet, some rights reserved (CC-BY)
©David Jeffrey Ringer, some rights reserved (CC-BY-NC)
©David Jeffrey Ringer, some rights reserved (CC-BY-NC)
©Melissa Abdallah, some rights reserved (CC-BY-NC)
©Felix Harper, some rights reserved (CC-BY-NC)
©Felix Harper, some rights reserved (CC-BY-NC)
©Nathan Jones, some rights reserved (CC-BY)
©Nathan Jones, some rights reserved (CC-BY)
©Nathan Jones, some rights reserved (CC-BY)
©Nathan Jones, some rights reserved (CC-BY)
©Nathan Jones, some rights reserved (CC-BY)
©Corey Farwell, some rights reserved (CC-BY)
©Corey Farwell, some rights reserved (CC-BY)
©Corey Farwell, some rights reserved (CC-BY)
©Cabrillo National Monument, some rights reserved (CC-BY-NC)
©brhong, some rights reserved (CC-BY-NC)
©Alison Young, some rights reserved (CC-BY-NC)
©dlbowls, some rights reserved (CC-BY-NC)
©dlbowls, some rights reserved (CC-BY-NC)
©Rebecca Johnson, some rights reserved (CC-BY-NC)
©Rebecca Johnson, some rights reserved (CC-BY-NC)
©Alison Young, some rights reserved (CC-BY-NC)
©Mirko Schoenitz, some rights reserved (CC0)
©Karen L. Johnson, some rights reserved (CC-BY-NC)
©Alison Young, some rights reserved (CC-BY-NC)
©Alison Young, some rights reserved (CC-BY-NC)
©Joshua Doby, some rights reserved (CC-BY-NC)
©Constanza Farinha Gómez, some rights reserved (CC-BY-NC)
©nancyb398, some rights reserved (CC-BY-NC)
©Sally Anderson, some rights reserved (CC-BY-NC)
©Mary Spilman, some rights reserved (CC-BY-NC)
©Mary Spilman, some rights reserved (CC-BY-NC)
©kuroshio, some rights reserved (CC-BY-NC)
©Rosabel Miro, some rights reserved (CC-BY-NC)
©Rosabel Miro, some rights reserved (CC-BY-NC)
©dlbowls, some rights reserved (CC-BY-NC)
©Alison Young, some rights reserved (CC-BY-NC)
©Alison Young, some rights reserved (CC-BY-NC)
©Alison Young, some rights reserved (CC-BY-NC)
©Mikko Heikkinen, some rights reserved (CC-BY)
©Al Kordesch, some rights reserved (CC0)
©Al Kordesch, some rights reserved (CC0)
©Al Kordesch, some rights reserved (CC0)
©Al Kordesch, some rights reserved (CC0)
©Sequoia Janirella Wrens, some rights reserved (CC-BY-NC)
©Sequoia Janirella Wrens, some rights reserved (CC-BY-NC)
©Sequoia Janirella Wrens, some rights reserved (CC-BY-NC)
©vorphan, some rights reserved (CC-BY-NC)
©queentardigrada, some rights reserved (CC-BY-NC)
©Elizabeth Bettenhausen, some rights reserved (CC-BY-NC)
©Elizabeth Bettenhausen, some rights reserved (CC-BY-NC)
©Casey H. Richart, some rights reserved (CC-BY)
©Lorri Gong, some rights reserved (CC-BY-NC-ND)
©abisanford, some rights reserved (CC-BY-NC)
©abisanford, some rights reserved (CC-BY-NC)
©jorgelaras, some rights reserved (CC-BY-NC)
©Siena McKim, some rights reserved (CC-BY-NC)
©kyleelightbody, some rights reserved (CC-BY-NC)
©kyleelightbody, some rights reserved (CC-BY-NC)
©jon_moore, some rights reserved (CC-BY-NC)
©Madeleine Claire, some rights reserved (CC-BY)
©Madeleine Claire, some rights reserved (CC-BY)
©Andrea Kreuzhage, some rights reserved (CC-BY-NC)
©Erasmo Macaya, some rights reserved (CC-BY)
©octonaut, some rights reserved (CC-BY-NC)
©ijones, some rights reserved (CC-BY-NC)
©ijones, some rights reserved (CC-BY-NC)
©sophieec, some rights reserved (CC-BY-NC)
©sophieec, some rights reserved (CC-BY-NC)
©Diego Almendras, some rights reserved (CC-BY)
©Diego Almendras, some rights reserved (CC-BY)
©Diego Almendras, some rights reserved (CC-BY)
©Diego Almendras, some rights reserved (CC-BY)
©heroicfauna, some rights reserved (CC-BY-NC)
©heroicfauna, some rights reserved (CC-BY-NC)
©heroicfauna, some rights reserved (CC-BY-NC)
©Amelia Tauber, some rights reserved (CC-BY)
©Amelia Tauber, some rights reserved (CC-BY)
©Amelia Tauber, some rights reserved (CC-BY)
©Amelia Tauber, some rights reserved (CC-BY)
©Amelia Tauber, some rights reserved (CC-BY)
©joseronchel, some rights reserved (CC-BY-NC)
©Valentina_Marín_Negrete, some rights reserved (CC-BY-NC)
©Valentina_Marín_Negrete, some rights reserved (CC-BY-NC)
©Jade Fortnash, some rights reserved (CC0)
©Jade Fortnash, some rights reserved (CC0)
©Jade Fortnash, some rights reserved (CC0)
©Jade Fortnash, some rights reserved (CC0)
©Jade Fortnash, some rights reserved (CC0)
©Jade Fortnash, some rights reserved (CC0)
©juliabohemian, some rights reserved (CC-BY-NC)
©juliabohemian, some rights reserved (CC-BY-NC)
©Dr. Alison Northup, some rights reserved (CC-BY)
©Dr. Alison Northup, some rights reserved (CC-BY)
©James Bailey, some rights reserved (CC-BY-NC)
©James Bailey, some rights reserved (CC-BY-NC)
©jlbanks, some rights reserved (CC-BY-NC)
©jlbanks, some rights reserved (CC-BY-NC)
©jlbanks, some rights reserved (CC-BY-NC)
©Nathan Jones, some rights reserved (CC-BY)
©Nathan Jones, some rights reserved (CC-BY)
©Nathan Jones, some rights reserved (CC-BY)
©Nathan Jones, some rights reserved (CC-BY)
©Nathan Jones, some rights reserved (CC-BY)
©Nathan Jones, some rights reserved (CC-BY)
©Nathan Jones, some rights reserved (CC-BY)
©Nathan Jones, some rights reserved (CC-BY)
©Nathan Jones, some rights reserved (CC-BY)
©Nathan Jones, some rights reserved (CC-BY)
©Nathan Jones, some rights reserved (CC-BY)
©Nathan Jones, some rights reserved (CC-BY)
©Nathan Jones, some rights reserved (CC-BY)
©levent90, some rights reserved (CC-BY-NC)
©levent90, some rights reserved (CC-BY-NC)
©levent90, some rights reserved (CC-BY-NC)
©Lexi Amico, some rights reserved (CC-BY)
©Lexi Amico, some rights reserved (CC-BY)
©Lexi Amico, some rights reserved (CC-BY)
©Lexi Amico, some rights reserved (CC-BY)
©Lexi Amico, some rights reserved (CC-BY)
©Lexi Amico, some rights reserved (CC-BY)
©Lexi Amico, some rights reserved (CC-BY)
©Lexi Amico, some rights reserved (CC-BY)
©Lexi Amico, some rights reserved (CC-BY)
©Joe MDO, some rights reserved (CC-BY-NC)
©Michelle Delaloye, some rights reserved (CC-BY-NC)
©juliabohemian, some rights reserved (CC-BY-NC)
©juliabohemian, some rights reserved (CC-BY-NC)
©Nikhil Reddy, some rights reserved (CC-BY-NC)
©LSchare (she/her), some rights reserved (CC-BY-NC)
©Joe MDO, some rights reserved (CC-BY-NC)
©JJ Johnson, some rights reserved (CC-BY-NC)
©JJ Johnson, some rights reserved (CC-BY-NC)
©JJ Johnson, some rights reserved (CC-BY-NC)
©goodsteph, some rights reserved (CC-BY-NC)
©sea-kangaroo, some rights reserved (CC-BY-NC-ND)
©Randal, some rights reserved (CC0)
©Randal, some rights reserved (CC0)
©Randal, some rights reserved (CC0)
©Randal, some rights reserved (CC0)
©Vishals_Lab, some rights reserved (CC-BY-NC-SA)
©Joshua Doby, some rights reserved (CC-BY-NC)
©Michele Reniche, some rights reserved (CC-BY-NC)
©Steven Kurniawidjaja, some rights reserved (CC-BY-NC)
©Bob McDougall, some rights reserved (CC-BY-NC)
©Jess Miller-Camp, some rights reserved (CC-BY-NC)
©carel van der Colff, some rights reserved (CC-BY-NC)
©Diego Almendras, some rights reserved (CC-BY)
©Diego Almendras, some rights reserved (CC-BY)
©Diego Almendras, some rights reserved (CC-BY)
©Saskia Raether, some rights reserved (CC-BY-NC)
©Saskia Raether, some rights reserved (CC-BY-NC)
©Saskia Raether, some rights reserved (CC-BY-NC)